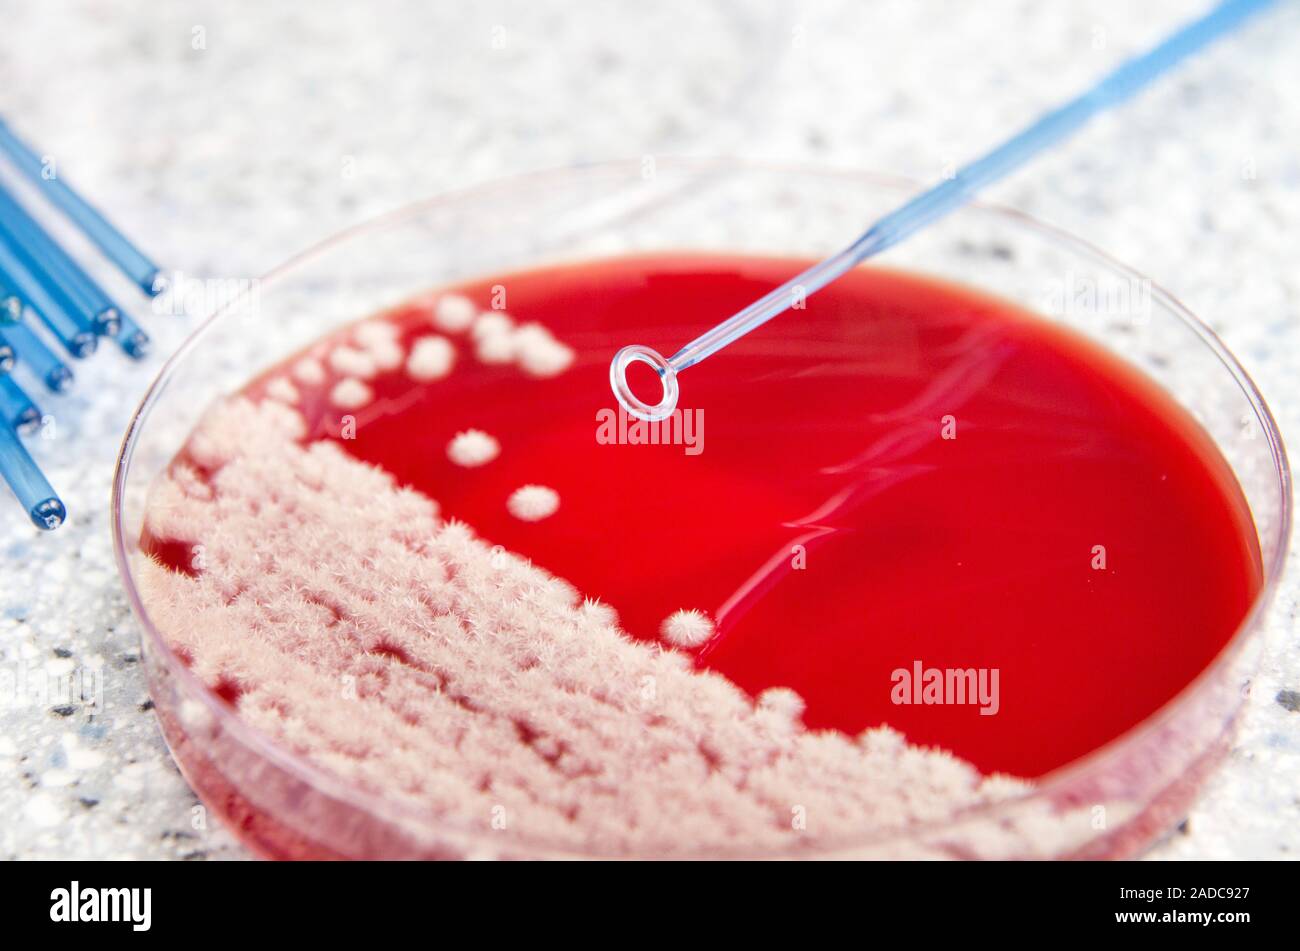

Candid Library Feet
Creampie Babes
Stu And Blake Bareback
Ilfenesh Hadera Naked
Masturbating jilling orgasm squirt Masturbation
Dominant 1080
Early morning sex with young blonde enchantress Bailey Brooks
Gif raped girl porn
Young Bikini Slip
Thick Blond MILF 3
Nudist Magazine
Russian boy fuck mature mom at home 23
Tea Time in Russian Federation
Macromancy forbiden magic superdom booty huge
Candid Library Feet 114 photos